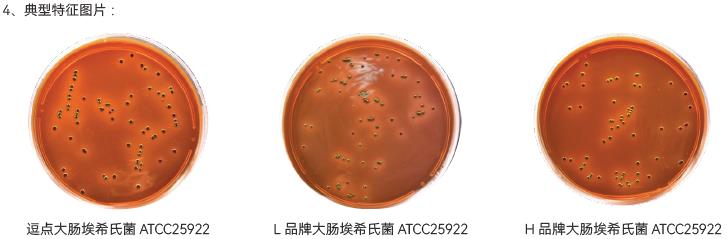
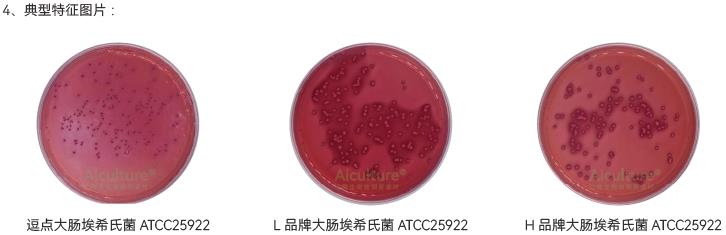

GB4789.6-2016致泻大肠埃希氏菌检验及注意事项
一、概述
大肠埃希菌(Escherichia coli)隶属于肠杆菌科,为革兰阴性短小杆菌,多数菌株具有周生鞭毛,能运动,无芽胞,兼性厌氧。能发酵多种糖类,产酸、产气。大肠埃希菌是人类和动物肠道中的正常栖居菌,其代谢活动能够抑制肠道内分解蛋白质的微生物的生长,减少蛋白质分解产物对人体的危害,还能够合成维生素B和维生素K供机体利用,同时也能够合成具有杀菌作用的大肠杆菌素,抑制腐败菌、致病菌和真菌的增殖。20世纪中叶,人们发现大肠埃希菌中的一些特殊血清型能够引起人类和动物疾病,尤其是对于免疫力低下者,常引起严重腹泻、败血症和溶血性尿毒综合征(HUS)等疾病,这类大肠埃希菌统称为致泻大肠埃希菌(又称致病性大肠埃希菌)。根据毒力因子、致病机制和流行病学特征,世界上公认的致泻大肠埃希菌致病型别主要分为5类:肠道致病性大肠埃希菌(Enteropathogenic E.coli,EPEC)、肠道侵袭性大肠埃希菌(Enteroinvasive E.coli,EIEC)、产肠毒素大肠埃希菌(Enterotoxigenic E.coli,ETEC)、产志贺毒素大肠埃希菌(Shigatoxin-producing E.coli,STEC)和肠道集聚性大肠埃希菌(Enteroaggregative E.coli,EAEC)。
EPEC是指能够引起宿主肠黏膜上皮细胞黏附及擦拭性损伤,且不产生志贺毒素的大肠埃希菌。该菌是婴幼儿腹泻的主要病原菌,有高度传染性,严重者可致死。EPEC的致病机制包括局限性黏附、信号传导和紧密黏附。其中,局限性黏附由存在于EAF质粒上的束状菌毛基因bfp介导;位于LEE毒力岛上的Ⅲ型分泌系统编码基因esc参与信号传导,引起微绒毛结构消失;而紧密黏附由外膜蛋白紧密素介导,紧密素由eae基因编码。
EIEC是指能够侵入肠道上皮细胞而引起痢疾样腹泻的大肠埃希菌。该菌不像典型的大肠埃希菌,无动力、不发生赖氨酸脱羧反应、不发酵乳糖,生化反应和抗原结构均近似痢疾志贺菌。侵入上皮细胞的关键基因是侵袭性质粒上的抗原编码基因及其调控基因,如ipaH基因、ipaR基因(又称为invE基因)。
ETEC是指能够分泌热稳定性肠毒素或(和)热不稳定性肠毒素的大肠埃希菌。热稳定性肠毒素按照来源不同分为猪源热稳定性肠毒素和人源热稳定性肠毒素,编码基因分别为stp(又称为stla)和sth(又称为stlb);热不稳定性肠毒素编码基因为It。两种肠毒素基因在ETEC中可单独存在,也可同时存在。该菌可引起婴幼儿和旅游者腹泻,一般呈轻度水样腹泻,也可呈严重的霍乱样症状,低热或不发热。腹泻常为自限性,一般2~3天即自愈。
STEC是指能够产生志贺毒素的大肠埃希菌。志贺毒素的编码基因为stx,志贺毒素分为两种类型,其编码基因分别为stx1和stx2,两者之间无免疫交叉反应。stx1和stx2在STEC中可单独存在,也可同时存在。目前,STEC包含的血清型有400种以上,其中一些血清型在临床上能够引起人类出血性结肠炎(HC)或出血性腹泻,并可进一步发展为溶血性尿毒综合征(HUS),这类STEC称为肠道出血性大肠埃希菌(Enterohemorhagic E.coli,EHEC)。EHEC可引起宿主肠黏膜上皮细胞黏附及擦拭性损伤,表现为微绒毛结构消失和紧密黏附,分别由esc编码的Ⅲ型分泌系统和eae编码的紧密素介导。其中,大肠埃希菌O157:H7是最主要、引起暴发最常见的EHEC血清型。二、检验程序
致泻大肠埃希氏菌检验程序
2.1样品的检验前准备
2.1.1 冷冻样品
检验前应先解冻,应保持原包装在45℃以下不超过15分钟或在2~5℃不超过18小时解冻。解冻后应立即进行检验,一旦解冻就不可再次冷冻。
2.1.2 液体或半固体样品
取样前应先将其充分摇匀。
2.1.3干燥粉状或颗粒状样品
取样前应先混合均匀。
2.1.4 固体样品
可用无菌镊子或剪刀剪碎,将样品搅拌均匀。应取样品的可食用部分进行检测,如是动物性样品,应避免取骨头作为检样。
2.2样品的制备
2.2.1 固体和半固体样品
2.2.1.1取样
以无菌操作用天平称取25g混合均匀的样品,加入盛有225ml灭菌营养肉汤的无菌均质杯或均质袋中。
2.2.1.2均质
如使用无菌均质杯,则用旋转刀片式均质器以8000~10000r/min均质1~2分钟;如使用无菌均质袋,则用拍击式均质器均质1~2分钟,制成1:10的样品匀液。注:如使用旋转刀片式均质器,样品均质时间超过2分钟,应在均质杯外加冰水冷却。
2.2.2 液体样品
2.2.2.1 非黏性液体样品(黏度不大于牛乳)
用无菌吸管吸取25ml混合均匀的样品,加入盛有225ml灭菌营养肉汤的无菌锥形瓶(瓶内可预置适当数量的无菌玻璃珠)或均质袋(或其他适宜的无菌容器))中,振荡混匀,制成1:10的样品匀液。
2.2.2.2黏性液体样品
以无菌操作用天平称取25g混合均匀的样品,加入盛有225ml灭菌营养肉汤的无菌锥形瓶(瓶内可预置适当数量的无菌玻璃珠)或均质袋(或其他适宜的无菌容器)中,振荡混匀,制成1:10的样品匀液。
2.3增菌
将上述制备好的样品匀液于36℃±1℃培养6小时,进行预增菌。无菌操作取预增菌液10μL,接种于30mL肠道菌增菌肉汤管内,涡旋或振荡混匀,于42℃±1℃培养18小时。
2.4分离
2.4.1使用直径3mm(约10μL)的接种环,分别取肠道菌增菌肉汤管内的增菌液1环,划线接种于MAC和EMB琼脂平板,于36℃±1℃培养18~24小时。
2.4.2 培养结束后,观察菌落特征。在MAC琼脂平板上,分解乳糖的典型菌落为砖红色至桃红色,不分解乳糖的菌落为无色或淡粉色;在EMB琼脂平板上,分解乳糖的典型菌落为中心紫黑色带或不带金属光泽,不分解乳糖的菌落为无色或淡粉色。
2.5生化试验
2.5.1 如果MAC和(或)EMB琼脂平板上有致泻大肠埃希菌的典型或可疑菌落(发酵乳糖和不发酵乳糖的菌落均可能为目标菌),应从每个琼脂平板上挑取10~20个(10个以下全选)可疑菌落,不但要挑取乳糖发酵的菌落,同时也要挑取乳糖不发酵和迟缓发酵的菌落。使用接种针自单个菌落中心挑取可疑菌落,接种TSI琼脂斜面培养基(先在TSI琼脂斜面划线,再于底层穿刺),接种针不要灭菌,直接接种营养琼脂平板,于36℃±1℃培养18~24小时。
2.5.2对于TSI斜面上生长现象初步判断为疑似大肠埃希菌的可疑菌落,从营养琼脂平板上挑取其纯培养物,按照所使用的生化试剂盒说明书,分别接种蛋白胨水(靛基质试验)、尿素琼脂(pH7.2)和KCN肉汤(包括试验管和对照管),于36℃±1℃培养18~24小时。
2.5.3 TSI斜面产酸或不产酸,底层产酸,靛基质阳性,H₂S阴性和尿素酶阴性的培养物为大肠埃希菌。TSI斜面底层不产酸,或H₂S、KCN、尿素有任一项为阳性的培养物,均非大肠埃希菌。必要时做革兰染色和氧化酶试验。大肠埃希菌为革兰阴性杆菌,氧化酶阴性。参照图对TSI、靛基质、尿素、KCN和氧化酶试验的结果进行判定。
2.5.4如选择生化鉴定试剂盒或微生物鉴定系统,可从营养琼脂平板上挑取可疑菌落的纯培养物,按照生化鉴定试剂盒或微生物鉴定系统配套试剂盒的说明书,对可疑菌落进行鉴定。
2.6 PCR确认试验(略)
三、检验注意事项
3.1 质量控制
3.1.1实验中使用的培养基和试剂每批次均应按照CB4789.28的规定进行验收和性能测试,并做好相关记录。
3.1.2实验过程中,增菌、分离、生化鉴定等各个环节均应对培养基和试剂做空白对照。若空白对照出现微生物生长,本次实验结果无效,应立即分析原因,对实验环境、培养基、试剂、取样器具、吸管、平皿等耗材进行检查处理。
3.1.3每次PCR反应使用EPEC、EIEC、ETEC、STEC/EHEC、EAEC标准菌株基因组DNA作为阳性对照,使用大肠埃希菌ATCC 25922或等效标准菌株基因组DNA作为阴性对照,以灭菌去离子水作为空白对照,监控PCR反应的有效性以及体系是否存在污染。
3.1.4 EPEC、EIEC、ETEC、STEC/EHEC、EAEC标准菌株应从专业微生物保藏机构、同行认可的专业权威机构或有资质的商业派生菌株生产厂家等认可的途径获得,菌株应经过验证后方可保存使用。
3.1.5定期使用致泻大肠埃希菌标准菌株污染样品,作为阳性对照进行质控,一般每25g(ml)样品的人工污染致病菌量应控制在10~100CFU之间。分析结果并做好记录,质控频次建议每月一次。
3.2操作要点和注意事顶
3.2.1 对易产生较大颗粒的样品和吸水后易膨胀的样品进行检测时,建议使用带滤网的均质袋,以方便后续实验过程中吸取样品增菌液。
3.2.2增菌后的所有操作均应在生物安全二级实验室进行,操作时应有相应的防污染措施,在进行可能产生气溶胶的操作时,应在生物安全柜内完成。菌液若有溢撒,应先用纱布轻轻覆盖溢撒处,由周边向溢撒中心喷洒或倾倒消毒剂(如75%乙醇,碘伏、1%次氯酸钠等),作用30分钟以上再进行后续处理。
3.2.3实验过程中应尽量使用移液管进行移液操作,因移液器枪头较短,枪体容易沾染菌液,导致交叉污染。必须使用微量移液器时,应慢慢吸取,并使用带有滤芯的吸头,防止增菌液对移液器的污染。移液管顶端应加塞棉花,防止液体倒吸进入洗耳球或配套的电动移液器,一旦进入,应立即进行清洁和消毒,防止交叉污染。
3.2.4在培养箱中进行培养时,平皿的堆叠高度不应超过6皿,以防止中间平皿温度偏高和形成厌氧微环境,影响微生物的生长。
3.2.5 生化试验和PCR确认试验,均应使用单个可疑菌落的纯培养物。必要时可使用MAC琼脂平板或EMB琼脂平板对可疑菌落进行二次纯化,再划线于营养琼脂平板培养,以保证试验结果的准确和可靠。
3.2.6 基于三糖铁试验的原理,配制三糖铁琼脂斜面培养基时,要保证斜面部分和管下部琼脂的长度,以保证两部分相对应的有氧和厌氧环境,一般要求琼脂底部与斜面最低点的距离应不少于4cm;用接种针穿刺时,宜穿刺至距培养基底部3~5mm处;培养时,应将试管口适当松开,保持管内有充足的氧气,避免由于氧气的不足导致斜面酸性产物不能氧化而出现假阳性现象(黄色)以及产生过量的H₂S影响结果的观察和判断。
3.2.7 PCR确认试验的实验环境和实验操作应符合食品分子生物学检测的要求,注意预防污染。使用和处理溴化乙锭染料等有毒有害物质时,应注意实验人员的安全防护和对环境的保护。
3.2.8 血清学试验时,首先要进行菌体的自凝性检查,自凝的菌株不能直接做血清凝集实验,需要转种几代,如果仍然自凝,可放弃血清凝集;大肠埃希菌的H抗原在传代过程中容易丢失或发育不良,可用半固体琼脂培养基3次传代培养,并观察生长情况,若扩散生长,可进行血清凝集试验;若不扩散生长,则表示H抗原丢失,可不再进行血清凝集试验。
3.2.9所有实验废弃物均应进行无害化处理,带菌废弃物一般采用高压蒸汽灭菌(121℃,30分钟)处理。
四、疑难解析
4.1 食品微生物检验中“重量和容量”的精确度要求?
GB4789系列食品微生物检验标准中未对重量和容量的精确度进行规定,可参考美国农业部食品安全检查局《微生物实验室指南》(Microbiology Laboratory Guidebook,MLG)和ISO标准中的相关规定。MLG“General Considerations”中规定“重量和容量的波动范围为±1%”;ISO7218:2007中规定“除另有说明,取样时允许的最大误差应为1%或更低”。
4.2大肠菌群、粪大肠菌群、大肠埃希菌和致泻大肠埃希菌的区别?
大肠菌群,是指在36℃培养条件下能发酵乳糖、产酸产气的需氧和兼性厌氧革兰阴性无芽胞杆菌,其可能来自人类和温血动物的肠道及自然环境,包括埃希菌属、柠檬酸菌属、克雷伯菌属和肠杆菌属等;粪大肠菌群,又称耐热大肠菌群,是一群在44.5℃培养24~48小时能发酵乳糖、产酸产气的需氧和兼性厌氧革兰阴性无芽胞杆菌,主要由大肠埃希菌组成,还包括与粪便污染无直接相关性的其他菌株,如肺炎克雷伯菌;大肠埃希菌隶属肠杆菌科埃希菌属,其广泛存在于人和温血动物的肠道中,是革兰阴性无芽胞杆菌,能够在44.5℃发酵乳糖产酸产气,IMViC生化试验结果为“++--”或“-+--”;致泻大肠埃希菌是一类能引起人体以腹泻症状为主的大肠埃希菌,主要包括肠道致病性大肠埃希菌、肠道侵袭性大肠埃希菌、产肠毒素大肠埃希菌、产志贺毒素大肠埃希菌(包括肠道出血性大肠埃希菌)和肠道集聚性大肠埃希菌。下图显示了大肠菌群、粪大肠菌群、大肠埃希菌和致泻大肠埃希菌的分类关系。
4.3挑取致泻大肠埃希菌可疑菌落时,为什么“不但要挑取乳糖发酵的菌落,同时也要挑取乳糖不发酵和迟缓发酵的菌落"?
绝大部分大肠埃希菌为乳糖发酵菌株,但致泻大肠埃希菌中的EIEC不像典型的大肠埃希菌,其生化反应和抗原结构近似痢疾志贺菌,不发酵乳糖。
4.4致泻大肠埃希菌检验涉及的生化试验原理是什么?
4.4.1 三糖铁试验 广泛用于肠杆菌科细菌的鉴定,通过观察细菌对糖的利用和硫化氢的产生,获得对细菌种属的初步判断。三糖铁琼脂培养基含有乳糖、蔗糖和葡萄糖的比例为10:10:1。如细菌只利用葡萄糖,葡萄糖被分解后产酸可使斜面先呈黄色,但因葡萄糖量少,生成的少量酸可因接触空气而氧化,加之细菌生长繁殖利用培养基中的含氮物质生成碱性化合物,使斜面部分后来又变成红色;底层由于处于缺氧状态,生成的酸类不被氧化而仍保持黄色。如细菌能够利用乳糖或蔗糖,产生大量的酸,使培养基斜面与底层均呈现黄色;同时也会产气,使培养基出现气泡或断层。某些细菌能分解含硫氨基酸,生成硫化氢,硫化氢和培养基中的铁盐反应,生成黑色的硫化亚铁沉淀,使培养基呈现黑色。常见的三糖铁试验有以下几种反应:a.斜面产碱/底层产碱:不发酵葡萄糖、乳糖和蔗糖,是非发酵型细菌的特征,如铜绿假单胞菌;b.斜面产碱/底层产酸:发酵葡萄糖、不发酵乳糖和蔗糖,是不发酵乳糖型细菌的特征,如志贺菌;c.斜面产碱/底层产酸(黑色):发酵葡萄糖、不发酵乳糖和蔗糖、产生硫化氢,是产硫化氢不发酵乳糖型细菌的特征,如大多数的沙门菌、柠檬酸杆菌和变形杆菌等;d.斜面产酸/底层产酸:发酵葡萄糖、乳糖、蔗糖,是发酵乳糖型细菌的特征,如大肠埃希菌、克雷伯菌属和肠杆菌属等。
4.4.2靛基质试验 某些细菌(如大肠埃希菌)可分解蛋白质中的色氨酸,产生靛基质(吲哚),靛基质与试剂中的二甲氨基苯甲醛结合,生成玫瑰色的靛基质。两层液体交界处出现红色为阳性,无色为阴性。
4.4.3尿素试验 某些细菌能产生尿素酶,将培养基中的尿素分解并产生氨,使培养基变为碱性,培养基中的指示剂酚红在碱性条件下由黄色变为粉红色。尿素酶的最适pH为7.0。
4.4.4氰化钾试验 氰化钾是细菌呼吸链末端的抑制剂,可与呼吸酶作用使酶失去活性,抑制细菌的生长,但有的细菌在一定浓度的氰化钾存在时仍能生长,以此对细菌进行鉴别。
4.4.5氧化酶试验 氧化酶即细胞色素氧化酶,是细胞色素呼吸酶系统的终末呼吸酶。氧化酶先使细胞色素C氧化,然后氧化型的细胞色素C再使对氨基二甲苯胺氧化,产生颜色反应。如使用Kowacs试剂,阳性反应呈粉红色至深紫色;使用Ewing改进试剂,阳性反应呈蓝色;阴性反应不发生颜色变化。氧化酶试验用于区分不发酵的革兰阴性杆菌(氧化酶阳性)和肠道菌(氧化酶阴性)。
4.5 是否可以不进行生化试验,根据特征毒力基因检测结果对致泻大肠埃希菌的型别进行判定?
按照GB4789.6—2016的规定,需要先对可疑菌落进行生化试验,生化试验符合大肠埃希菌特征后,再进行毒力基因的检测,从而判定致泻大肠埃希菌的型别。在肠杆菌科中,其他一些致病菌也存在相同的毒力基因。因此,需先通过生化试验排除这类细菌,再进行毒力基因检测,以确认致泻大肠埃希菌型别。
4.6 escV和ere等效基因是同时存在吗?在PCR确认试验过程中选做其中一个即可吗?
GB4789.6—2016规定:“escV和eae基因选做其中一个”“在判定EPEC或SETC/EHEC时,escV和eae基因等同效果”。escV和eae基因是EPEC和STEC/EHEC的特征毒力基因。escV基因位于LEE毒力岛,负责编码Ⅲ型分泌系统的功能基因;eae基因位于染色体上,负责细菌和肠黏膜细胞的紧密黏附,二者在致病的不同阶段起重要作用。两个基因在试验过程中选做其中一个即可。一般情况下,两个基因同时存在,但不排除传代过程中基因丢失,或试验条件不符合导致其中一个基因检测不出等特殊情况。
4.7 血清学试验在何种情况下需要进行?
一般情况下,根据特征毒力基因检测结果可确认样品中致泻大肠埃希菌型别,不需要进行血清学试验。在食源性疾病暴发溯源调查时,血清学分型简便易行,在确定了致泻大肠埃希菌型别后,可以快速对不同来源菌株的同源性进行初步判断,利于溯源调查。
4.8如何看待不同致病型别致泻大肠埃希菌血清型别对照表中口抗原相互交叉的精况?
过去,人类对致泻大肠埃希菌致病机制研究不足,致泻大肠埃希菌的鉴定和不同致病型别的区分只能依据生化和血清型别进行判断。根据不同临床症状划分出致泻大肠埃希菌的致病型别后,再分析相对应的血清型别,形成了当前广泛应用的五种致病型别致泻大肠埃希菌与血清型别的对照表。随着分子生物学的快速发展,人类对致泻大肠埃希菌的致病机制有了充分的认识,并明确了不同致病型别致泻大肠埃希菌的特征毒力基因,也逐渐发现了血清型别鉴定致泻大肠埃希菌致病型别的不足之处。血清型判定依据是菌体抗原(O抗原、H抗原和K抗原),这些抗原并不是致泻大肠埃希菌发病的根本原因。因此,根据血清型别判定的致泻大肠埃希菌并非都有致病力,也出现了相同“血清型”归属于不同致病型别的情况,即对照表中O抗原存在交叉的情况。有数据显示在研究EPEC时,血清型别与致病型别的一致性最高为78.4%,最低仅为3%。
参考文献
[1]国家食品药品监督管理总局科技和标准司.微生物检验方法食品安全国家标准实操指
南[M].北京:中国医药科技出版社,2017.
[2]刘云国.食品卫生微生物学标准鉴定图谱[M].北京:科学出版社,2009.附录A
营养肉汤(NB)1、产品用途:用于一般细菌培养、复壮、增菌等,也可用于消毒剂定性消毒效果测定。
2、检验原理:蛋白胨和牛肉膏粉提供氮源、维生素、氨基酸和碳源;氯化钠能维持均衡的渗透压。
3、营养肉汤(NB)验证数据


5、验证结果小结:
1、生长率:目标菌大肠埃希氏菌ATCC25922 、鼠伤寒沙门氏菌 ATCC14028、金黄色葡萄球菌 ATCC6538,逗点、L品牌、H品牌的混浊度 、生长现象均满足要求;24±2h培养后浑浊度均达到2。
2、感观:逗点、L品牌、H品牌外观颜色无明显差异。附录B
肠道增菌肉汤1、产品用途:用于肠道菌的增菌培养。
2、检验原理:蛋白胨提供蛋白质、维生素和氨基酸;葡萄糖提供碳源;磷酸氢二钠和磷酸二氢钾为缓冲剂;牛胆盐和煌绿为选择性抑菌剂,抑制非肠杆菌科细菌的生长。
3、肠道增菌肉汤验证数据


5、验证结果小结:
1、生长率:目标菌大肠埃希氏菌ATCC25922 、阪崎肠杆菌 ATCC29544、,逗点、L品牌、H品牌的混浊度均满足要求;
2、选择性:金黄色葡萄球菌 ATCC6538,逗点、L品牌、H品牌满足不生长、抑制的要求;
3、感观:逗点、L品牌、H品牌并无明显差异。附录C
伊红美蓝(EMB)琼脂培养基验证1、产品用途:用于分离革兰氏阴性肠道菌特别是大肠菌群和粪大肠菌群。
2、检验原理:蛋白胨提供碳源和氮源;乳糖是大肠菌群可发酵的糖类;磷酸氢二钾是缓冲剂;琼脂是培养基凝固剂;伊红和美蓝是抑菌剂和 pH 指示剂,可抑制革兰氏阳性菌,在酸性条件下产生沉淀,形成紫黑色菌落或具黑色中心的外围无色透明的菌落。
3、伊红美蓝(EMB)琼脂培养基验证

5、验证结果小结:
1、生长率:目标菌大肠埃希氏菌 ATCC25922,逗点、L品牌、H品牌均满足国标PR≥0.5;黑色菌落,具金属光泽的要求;且三家无明显差异。
2、特异性:鼠伤寒沙门氏菌 ATCC14028,逗点、L品牌、H品牌均满足国标菌落呈无色、半透明;且三家无明显差异。
3.选择性:金黄色葡萄球菌 ATCC6538, 逗点、L品牌、H品牌均满足国标G<5的要求;且三家无明显差异。
4、感观:逗点、H品牌平板颜色无明显差异,L品牌平板颜色稍微深一点。附录D
麦康凯琼脂(MAC)验证1.产品用途:用于肠道致病菌的选择性分离培养。
2.检验原理:蛋白胨提供碳氮源;乳糖为可发酵的糖类;3号胆盐和结晶紫可抑制革兰氏阳性菌的生长;氯化钠维持均衡的渗透压;中性红是pH指示剂,细菌发酵乳糖产酸时菌落呈粉红色,并在菌落周围出现胆盐沉淀的浑浊圈。琼脂是培养基的凝固剂。
3.麦康凯琼脂(MAC)验证

5、验证结果小结:
1.生长率:目标菌大肠埃希氏菌ATCC25922,逗点、L品牌、H品牌均满足国标PR≥0.5的要求; 福氏志贺氏菌 CMCC(B)51572,逗点、L品牌、H品牌均满足国标PR≥0.5的要求。
2.选择性:金黄色葡萄球菌 ATCC6538 ,逗点、L品牌、H品牌均满足国标G≤1的要求。
3.感观:三家平板颜色无显著差异、逗点颜色稍微深一点点。